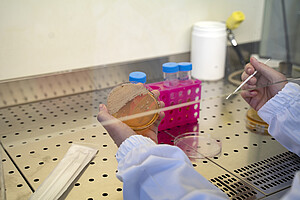

Date de publication : 16/03/22
Thèmes[Presse] Recherche [Presse] Vie de l'université
Magda Fusaro, rectrice de l’Université du Québec à Montréal (UQAM), a officiellement lancé ce matin le REseau International UNIversités-Société (RÉIUNIS), un réseau francophone qui valorise la recherche participative au sein des universités qui le composent.
La rencontre virtuelle s’est tenue à l’ouverture de la 4e édition du Printemps de la recherche et de la création de l’UQAM, en présence de représentant.es des universités Gaston-Berger du Sénégal, de Lausanne en Suisse, de Lyon 2, de Rennes 2 et de Strasbourg en France et de l’Université du Québec en Outaouais (UQO).
Les universités partenaires fondatrices de ce réseau :
- Université du Québec à Montréal (UQAM)
- Université de Strasbourg
- Université de Rennes 2
- Université de Lyon 2
- Université de Lausanne
- Université Laval
- Université du Québec en Outaouais (UQO).
L’Université Gaston-Berger s’apprête à rejoindre officiellement le réseau sous peu.
Formé à l’initiative de l’UQAM pour partager expériences et réflexions sur les coopérations entre les universités et la société, ce réseau francophone unique aspire à mieux faire connaître et reconnaître les recherches partenariales participatives et à améliorer les conditions, y compris financières, de leur exercice.
La recherche participative au cœur de l’existence de ce réseau
RÉIUNIS souhaite positionner les universités membres comme des joueurs de première importance dans la recherche participative (recherches collaboratives, coopératives, sciences citoyennes, etc.) qui vise à coconstruire des projets de recherche entre chercheuses et chercheurs et leur communauté. Bien que ce type de recherche permette de faire avancer des questions centrales pour l'ensemble de la société, il est encore peu connu et peu valorisé.
Le Réseau vise également à renouveler le sens des études supérieures : valoriser socialement les compétences scientifiques portées par les étudiantes et étudiants, créer du lien social en mettant en valeur leur engagement, apporter des solutions aux problématiques concrètes du terrain et favoriser l’émergence d’une nouvelle culture de chercheurs-citoyens.
Réunis autour de valeurs communes
RÉIUNIS a pour but de rassembler autour de valeurs reliées à la mission sociale des universités, des établissements francophones qui partagent cette vision afin de les promouvoir dans le cadre de politiques publiques et de stratégies, programmes et budgets de recherche et d’innovation. En définitive RÉIUNIS s’attaque sur le plan international à la question de la pertinence sociale de la recherche participative en partenariat avec des acteurs de la société civile, afin de consolider le développement et le soutien de ces pratiques dans les pays, villes, et établissements respectifs de ses membres.
« Faire participer les citoyens à la science est la meilleure manière de la démystifier et de lui rendre sa place et sa légitimité dans la société. Si l’arrivée du numérique a fait croire à un monde où tout serait ouvert, accessible, utilisable et façonnable à l’envi, si elle a mis au même niveau les opinions individuelles, les idéologies collectives et les savoirs construits (mais réfutables), il est temps de redonner à la science sa juste place. Ni dogme, ni décision politique, la science a vocation à éclairer la décision et à nous aider à résoudre les grands problèmes de notre temps et les questions du quotidien. Le Réseau REIUNIS lie entre elles des universités qui partage cette analyse et qui agissent pour mieux articuler science et société. Telle est aussi l’ambition et l’histoire de l’université de Strasbourg. »
Mathieu Schneider, vice-président Culture, sciences-société et actions solidaires de l’Université de Strasbourg.
Une première activité pour le réseau
Le lancement du RÉIUNIS a été suivi d’une table ronde en ligne animée par le vice-recteur à la Recherche, à la création et à la diffusion de l’UQAM, Christian Agbobli, autour de trois thèmes portant sur des enjeux communs :
La science participative ouverte
- Mathieu Schneider, vice-président Culture, sciences-société et actions solidaires, Université de Strasbourg.
- Sambou Ndiaye, professeur, Université Gaston-Berger, Sénégal
- Adel El Zaïm, vice-recteur à la recherche, à la création, aux partenariats et à l’internationalisation, UQO
L’engagement étudiant
- Julia Bonaccorsi, vice-présidente Sciences et société, Université Lumière Lyon 2
- Leszek Browkoski, vice-président de l’Université Rennes 2 : Culture, science et société
- Doris Farget, professeure, Département des sciences juridiques, UQAM et directrice du GRIAAC/CIÉRA-MTL
Le financement de la recherche participative
- Christian Agbobli, vice-recteur à la Recherche, à la création et à la diffusion. UQAM
- Alain Kaufmann, directeur du ColLaboratoire, Université de Lausanne
- Janice Bailey, directrice scientifique, Fonds de recherche du Québec en nature et technologies.
Pour aller plus loin : https://actualites.uqam.ca/2022/lancement-reseau-universites-societe
Vidéo de la table-ronde RÉIUNIS sur UQAM-TV : https://tv.uqam.ca/table-ronde-reseau-universites-societe-reiunis-15-mars-2022
Contacts presse :
Université de Strasbourg | Alexandre Tatay | tatay@unistra.fr | +33 (0)6 80 52 01 82
UQAM | Rose-Aline LeBlanc | leblanc.rose-aline@uqam.ca
Université de Lausanne | Géraldine Falbriard | Geraldine.Falbriard@unil.ch | +41 (0)21 692 20 66 | +41(0)79 897 30 14
Université Lyon 2 | Sandrine Barberino | s.barberino@univ-lyon2.fr | +33 (0)4 78 69 70 49 | +33 (0)6 43 42 20 06
Université Rennes 2 | Anaïg Blum Le Coat | anaig.blum-le-coat@univ-rennes2.fr | +33 (0)2 99 14 10 37 | +33 (0)6 12 52 42 58
Document à télécharger
- Nom du fichier : CP_lancement_REseau_Inter… Poids du fichier : 204 Ko